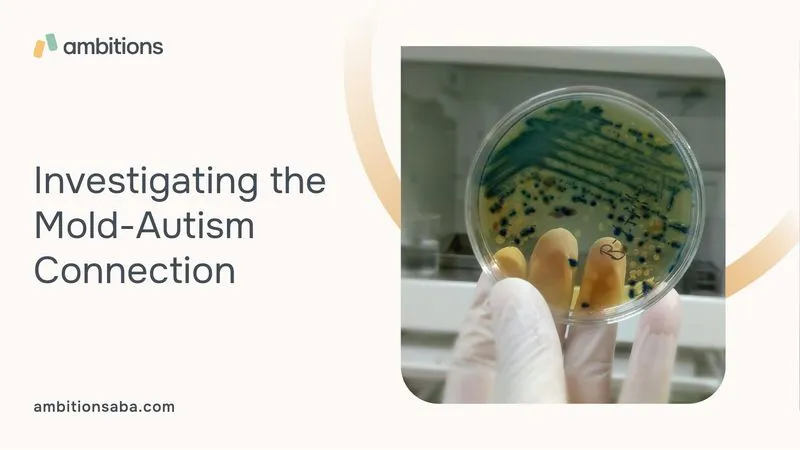

Mold Exposure and Autism
When exploring the potential causes of autism, researchers have taken a closer look at environmental factors that could contribute to its development. One such factor that has been the subject of investigation is mold exposure. In this section, we will delve into the topic of mold exposure and its possible connection to autism.

Understanding Autism
Autism, or Autism Spectrum Disorder (ASD), is a developmental disorder characterized by challenges in social interaction, communication, and repetitive behaviors. It is a complex condition with a wide range of symptoms and severity levels. While the exact causes of autism remain unclear, researchers believe that a combination of genetic and environmental factors may play a role.
The Link Between Environmental Factors and Autism
Environmental factors have gained significant attention in the search for potential triggers or contributors to autism. These factors encompass various elements in our surroundings that individuals are exposed to, both during pregnancy and early childhood. Researchers have identified a range of environmental factors that may influence autism risk, including exposure to pollutants, pesticides, and infections.
One environmental factor that has recently garnered interest is mold exposure. Mold is a type of fungus that can grow indoors in damp or humid environments. When mold spores are inhaled or come into contact with the skin, they can potentially trigger allergic reactions and respiratory issues. Some studies have suggested a correlation between mold exposure and certain health conditions, including autism.
While research in this area is ongoing, it is important to note that the exact mechanisms by which mold exposure may contribute to autism are not yet fully understood. The potential relationship between mold exposure and autism is complex, and further investigation is needed to establish a definitive link.
As we continue to unravel the potential connection between mold exposure and autism, it is important to approach the topic with caution. While mold prevention and management are essential for maintaining a healthy living environment, it is crucial to consult with healthcare professionals and experts in the field to fully understand the impact of mold exposure on individuals with autism.
The Basics of Mold Exposure
To understand the potential connection between mold exposure and autism, it is important to have a clear understanding of what mold is and how individuals can be exposed to it.
What is Mold?
Mold refers to a type of fungus that thrives in moist and damp environments. It can grow on various surfaces, such as walls, ceilings, carpets, and even food. Mold reproduces by releasing tiny spores into the air, which are then carried to other areas and can settle on different surfaces. These spores can be inhaled or come into contact with the skin.
There are many different types of mold, including common species like Aspergillus, Penicillium, and Stachybotrys chartarum (also known as black mold). Each type has its own characteristics and potential health effects.
Common Sources of Mold Exposure
Mold can be found both indoors and outdoors. However, indoor mold exposure is of particular concern, as individuals spend a significant amount of time in enclosed environments such as homes, schools, and workplaces.
Common sources of indoor mold include:
- Water Leaks and Moisture: Mold thrives in damp environments, making areas with water leaks, high humidity, or poor ventilation more susceptible to mold growth. These can include areas near plumbing fixtures, roofs, windows, or areas affected by flooding.
- Condensation: Areas with high condensation, such as bathrooms, kitchens, or basements, are prone to mold growth. Poor ventilation can exacerbate this issue.
- Damp Materials: Mold can grow on materials such as carpets, upholstery, wallpaper, and cardboard boxes if they become damp or wet.
- HVAC Systems: If not properly maintained, heating, ventilation, and air conditioning (HVAC) systems can become breeding grounds for mold. Dust, debris, and moisture within the system can create an ideal environment for mold growth.
- Potted Plants: Overwatering indoor plants or allowing excess moisture to accumulate in the soil can promote mold growth.
It is important to note that the presence of mold does not necessarily indicate a direct link to autism. However, understanding the basics of mold exposure is crucial in exploring the potential relationship between mold and autism.

Mold and Neurological Effects
Exposure to mold can have various effects on our health, including potential impacts on neurological function. In this section, we will explore the mold-related health issues that can arise from mold exposure and discuss the potential connection between mold and neurological conditions, such as autism.
Mold-Related Health Issues
Mold exposure can lead to a range of health issues, particularly for individuals who are more susceptible, such as those with compromised immune systems or pre-existing respiratory conditions. Common mold-related health issues include:
- Respiratory Symptoms: Mold spores can trigger respiratory symptoms, including coughing, wheezing, and shortness of breath, especially in individuals with asthma or allergies.
- Nasal and Sinus Congestion: Mold exposure can cause nasal congestion, sneezing, and sinus inflammation.
- Eye and Skin Irritation: Mold spores in the air can irritate the eyes and skin, leading to redness, itching, and rashes.
- Allergic Reactions: Some individuals may develop allergic reactions to mold, resulting in symptoms such as runny nose, itchy eyes, and skin reactions.
It's important to note that while exposure to mold can cause these health issues, the link between mold exposure and specific neurological conditions, such as autism, is still being studied.
Mold and Neurological Conditions
Research exploring the potential connection between mold exposure and neurological conditions, including autism, is ongoing. Autism is a complex developmental disorder that affects social interaction, communication, and behavior. While the exact causes of autism are still not fully understood, there is evidence to suggest that environmental factors, such as mold exposure, may play a role in its development.
Several studies have investigated the potential correlation between mold exposure and autism, although the findings have been mixed. Some studies have suggested a possible association between mold exposure during pregnancy or early childhood and an increased risk of autism. However, these studies are limited and more research is needed to establish a definitive link.
It is important to approach the topic of mold and its potential impact on neurological conditions with caution. While there is ongoing research, it is crucial not to jump to conclusions or make definitive claims about the relationship between mold exposure and autism.
As research continues, it is advisable to take precautionary measures to minimize mold exposure and maintain a healthy living environment for individuals with autism and their caregivers. This includes addressing any moisture or water issues in the home, proper ventilation, regular cleaning, and seeking professional help if needed.
Understanding the potential impact of mold exposure on neurological conditions is an ongoing area of research. It is important to stay informed, consult healthcare professionals, and create a safe and healthy environment for individuals with autism.
Investigating the Mold-Autism Connection
As researchers continue to explore the potential causes of autism, the link between mold exposure and the development of autism has garnered attention. While the exact relationship between the two remains under investigation, various research studies and findings suggest a possible connection. Additionally, it is vital to explore the plausibility of mold as a risk factor for autism.
Research Studies and Findings
Several studies have aimed to investigate the potential association between mold exposure and autism. While not conclusive, these studies have provided valuable insights into the topic.
For instance, a study published in Environmental Health Perspectives found an association between residential mold and increased odds of autism spectrum disorder (ASD) in children. However, it's important to note that this study relied on self-reported data, which may introduce limitations.
Another study published in the Journal of Autism and Developmental Disorders examined the impact of maternal mold exposure during pregnancy on the risk of autism in offspring. The research suggested a positive correlation, indicating that prenatal exposure to mold may contribute to the development of autism. However, further research is necessary to validate these findings and establish a more definitive connection.
Exploring the Plausibility of Mold as a Risk Factor
The plausibility of mold as a risk factor for autism lies in its potential to affect neurological function and the immune system. Mold exposure can lead to the release of mycotoxins, which are toxic substances produced by certain molds. These mycotoxins have been associated with various health issues, including respiratory problems, allergies, and immune system dysregulation.
It is believed that the immune system plays a role in the development of autism, as individuals with autism often exhibit immune system abnormalities. Some researchers hypothesize that mold-related illness and immune dysregulation may contribute to the development or exacerbation of autism symptoms in susceptible individuals.
However, it's important to approach this topic with caution. While an association between mold exposure and autism has been suggested, additional research is needed to establish a definitive causal relationship. Factors such as genetic predisposition, other environmental exposures, and individual susceptibility may also play a role in the development of autism.
To promote a healthy environment for individuals with autism and minimize potential risks, it is advisable to take measures to reduce mold exposure. This includes proper ventilation, controlling humidity levels, and promptly addressing any water damage or mold growth in the home. Seeking professional help, such as mold remediation specialists, can be beneficial in addressing mold issues effectively and ensuring a safe living environment.
While the investigation into the mold-autism connection continues, it is crucial to emphasize the importance of further research in unraveling the complex factors contributing to autism. Understanding the role of environmental factors, including mold exposure, can aid in developing strategies to support individuals with autism and provide a healthier environment for all.
Mold Prevention and Management
When it comes to mold exposure and its potential link to autism, prevention and management are key factors in creating a safe and healthy environment. By taking proactive steps to reduce mold exposure in the home, individuals can minimize potential risks. Here are two important strategies to consider: reducing mold exposure in the home and seeking professional help.
Reducing Mold Exposure in the Home
Preventing mold growth in the home is crucial for maintaining a healthy living environment, especially for individuals with autism. Here are some practical steps you can take to reduce mold exposure:
- Control moisture levels: Mold thrives in damp environments, so it's important to keep moisture levels in check. Repair any leaks or water damage promptly, and ensure proper ventilation in areas prone to moisture, such as bathrooms and kitchens.
- Monitor humidity: Use a dehumidifier in areas with high humidity to help control moisture levels. Aim for a relative humidity of around 30-50% to discourage mold growth.
- Promote good air circulation: Ensure proper airflow throughout the home by opening windows, using fans, and maintaining good ventilation systems. This helps to prevent stagnant air and moisture buildup.
- Address water intrusion: Regularly inspect your home for signs of water intrusion, such as leaks or condensation. Address any issues promptly to prevent mold growth.
- Clean and dry: Regularly clean and dry areas prone to moisture, such as bathrooms, kitchens, and basements. Pay attention to areas where moisture can accumulate, such as shower curtains, windowsills, and washing machines.
- Remove mold promptly: If you spot any mold growth, it's important to address it promptly. Use appropriate cleaning methods, such as a mixture of water and detergent, or a mild bleach solution for non-porous surfaces. Remember to wear protective gear, such as gloves and a mask, while cleaning.
Seeking Professional Help
In some cases, mold issues may be more complex or widespread, requiring professional assistance. If you suspect a significant mold problem in your home, consider seeking help from professionals with expertise in mold remediation. They can assess the extent of the mold issue, identify the source of moisture, and provide appropriate remediation strategies.
Professional mold remediation may involve:
- Mold testing: Professionals can conduct mold testing to identify the type and concentration of mold present in your home.
- Mold removal and cleanup: Trained professionals can safely remove mold and address the underlying moisture issues to prevent future growth.
- Repair and restoration: Depending on the extent of the damage, professionals may also provide repair and restoration services to restore your home to a safe and healthy condition.
Remember, it's important to prioritize the health and well-being of individuals with autism by creating a mold-free environment. By implementing preventative measures and seeking professional help when necessary, you can reduce the risks associated with mold exposure.
Key Takeaways
The possible connection between mold exposure and autism is a topic that requires further research and investigation. While there have been studies exploring this link, it is important to approach the subject with caution and continue to gather more evidence. Here are a few key takeaways to keep in mind:
The Importance of Further Research
Understanding the potential relationship between mold exposure and autism is an ongoing area of scientific inquiry. Current research indicates that environmental factors, including mold exposure, may play a role in the development of autism. However, it is important to note that the exact mechanisms and extent of this connection are still being explored.
To gain a comprehensive understanding of the mold-autism relationship, further research is needed. Studies should focus on larger sample sizes, diverse populations, and rigorous methodologies to provide more conclusive evidence. Additionally, investigating the specific mechanisms by which mold exposure may contribute to the development or exacerbation of autism will help shed more light on this complex issue.
Promoting a Healthy Environment for All
Regardless of the definitive link between mold exposure and autism, it is crucial to prioritize a healthy environment for individuals with autism and their caregivers. Mold can have various negative health effects, including respiratory issues and allergic reactions. Taking steps to prevent and manage mold growth in homes and other indoor spaces is beneficial for everyone's well-being.
To reduce mold exposure, it is important to address moisture issues promptly, such as fixing leaks and ensuring proper ventilation. Regularly cleaning and maintaining areas prone to mold growth, such as bathrooms and basements, can also help minimize the risk. Seeking professional help, such as mold remediation experts, can provide expert guidance and assistance in managing mold issues effectively.
By promoting a healthy environment that minimizes mold exposure, we can contribute to the overall well-being of individuals with autism and their families.
As research continues to advance, it is essential to stay informed about the latest findings and recommendations regarding mold exposure and autism. By considering the potential risks and taking proactive steps to maintain a healthy living space, we can create environments that support the health and well-being of individuals with autism and their families.



